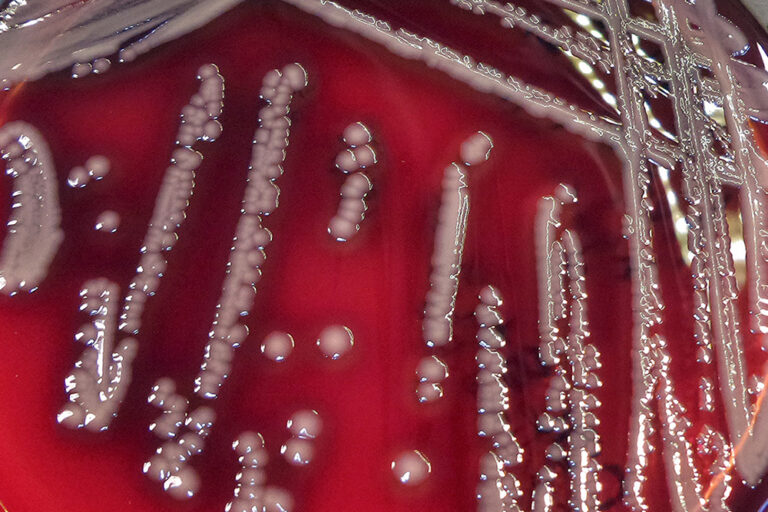

Health & Welfare
Aquaculture and Aeromonas hydrophila: A complex interplay of environmental factors and virulence
Solving the mechanisms of environmental virulence regulation can help develop targeted interventions to mitigate A. hydrophila infections.











